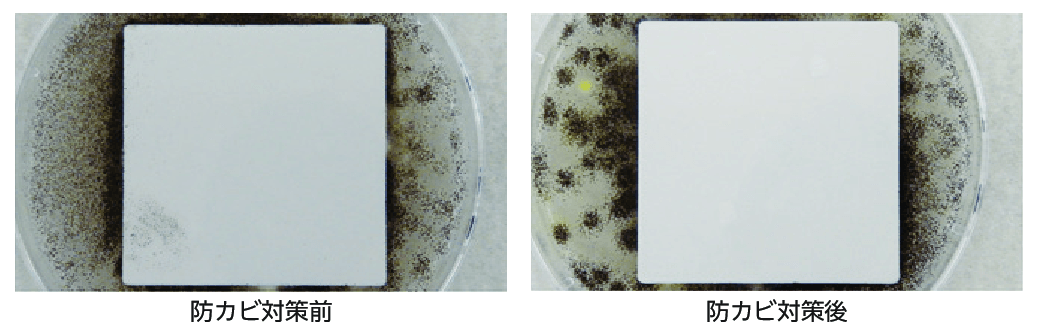

業界初 「全面 抗ウイルス・抗菌・防カビ仕様のテーブル」 発売!
脚まで抗ウイルス・抗菌・防カビの安心設計
椅子とベッド用資材のリーディングカンパニー、シンコー株式会社はこの度、天板のみでなく、テーブル脚まで
全て 抗ウィルス・抗菌・防カビ仕様のテーブル/天板を発売。脚まで抗ウイルス・抗菌・防カビのテーブルは業界初。飲食店は勿論、病院や各種施設を始め様々な商業スペースにも最適な商品。
「すわる」と「ねる」の資材のシンコー株式会社(本社:愛知県名古屋市中川区、代表取締役社長:矢追和彦)は、これまでに抗菌・抗ウイルスの機能を付与した“椅子張り生地(織物やPVCレザー)”の開発で培ったノウハウを活かし、全面 抗ウィルス・抗菌・防カビ仕様のテーブル/天板をブランチ事業部から発売すると発表した。
抗ウィルス・抗菌・防カビの安心設計のみでなく、デザイン性や1cm単位でオーダーに対応するなど多くの施設で御利用頂けるようにこだわりを詰め込んだ。

業界初!全面抗ウイルス・抗菌・防カビで安心をお届け
シンコー株式会社は椅子の張り地メーカー。これまで抗菌や防カビの衛生面や耐アルコール、耐次亜塩素酸のメンテナンス性など、様々な機能性商品を展開。最近では椅子張り地としてもいち早く抗ウィルスPVCレザーを発売する事でお客様に安心・安全をお届け続けて来た。
お客様へ“機能性椅子張り生地“をご提案する中で、「椅子のみでなく、テーブル、それもテーブル脚や天板の裏面も手が触れるので、全面が抗菌・抗ウィルス機能の製品でないと商業スペースでは安心とは言えないのではないか?」と言うお問い合わせをたくさん頂きました。
椅子張り生地の開発で培ったノウハウを活かし、椅子だけでなく、椅子とセットでご利用頂くテーブルからも安心を提供したい想いで製品化が実現。二次感染を増やさない事が店舗や施設に求められ、大切なお客様をウイルスや菌からお守りする。それがこれからの新しいの提案スタイル。

天板も脚も抗ウイルス・抗菌・防カビ塗装のこだわり
これまで業界内ではテーブル天板の表面にウイルス対策を施しているテーブルはあったが、小口(注1)から裏面、脚に至るまで、全て抗ウイルス・抗菌対策を施している製品は業界初。(注2)
怖いのはウイルスや菌だけではありません。日本人の主な死因は癌や心筋梗塞の他、最終的に命を落とす直接原因には免疫力低下による感染症が多く、カビからの感染症例も少なくありません。その為、防カビ効果も付与し、抗ウイルス・抗菌のみでなく、防カビ対策も万全です。

天板だけでなく脚の高さも1cm単位のオーダーに対応
こだわったのは安全性・機能面だけではありません。
多くの空間スペースで御利用いただけるようデザイン性も追求。
天板は角板・丸板に対応。色調は柾目・板目(注3)の木目調、単色カラーをご用意。
小口(注1)タイプもストレートタイプと舟底タイプの2種類。
又、天板サイズは勿論、脚の高さも1cm単位で御希望のサイズのオーダーに対応。様々なカラー、デザイン、サイズの組み合わせで高級感ある空間からカジュアルな空間まで場所やシーンを選びません。

注1:“こぐち“と呼ばれる天板の側面
注2:2021年3月現在 当社調べ
注3:材木を製材する際に出来る木目の方向
商品詳細はこちらのQRコードよりご確認下さい。